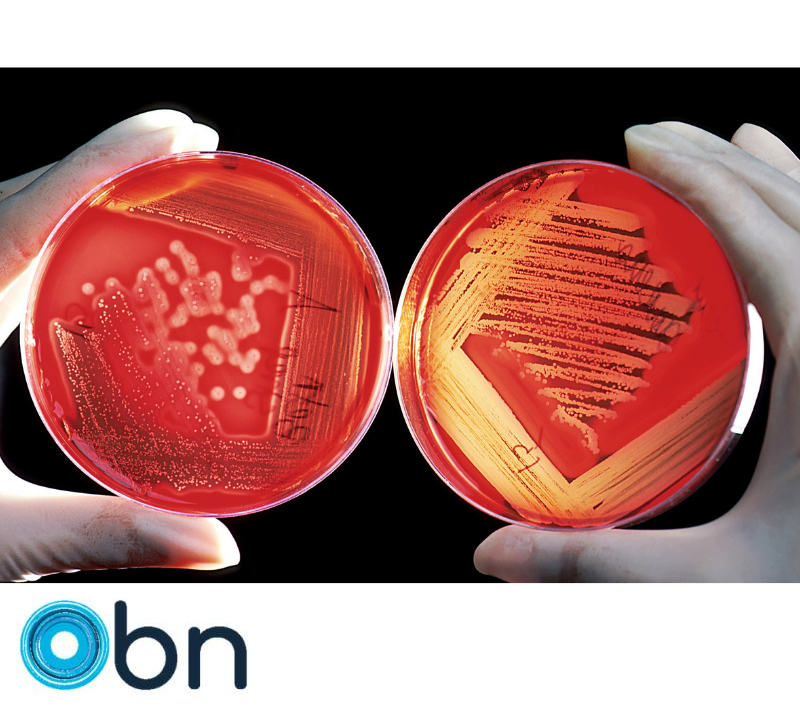

Günümüzde, küresel ısınma ve çevre kirliliği gibi çevresel sorunlar, bilim insanlarını sürdürülebilir enerji kaynakları arayışına yönlendirmiştir. Cornell Üniversitesi’ndeki araştırmacılar, güneş enerjisiyle çalışan mikropların CO2’nin biyoplastiklere dönüştürülmesini sağlayan yenilikçi bir yöntem geliştirerek, sürdürülebilir plastik üretimi alanında umut verici bir adım atmışlardır. Bu makalede, güneş enerjisiyle çalışan mikropların potansiyelini ve biyoplastik üretimindeki rolünü daha detaylı olarak inceleyeceğiz.
Biyoplastikler, geleneksel petrokimyasal plastiklerin aksine, biyolojik kaynaklardan elde edilen ve doğada çevre dostu bir şekilde çözünebilen plastiklerdir. Bu nedenle, biyoplastikler, plastik atık sorununu hafifletme ve fosil yakıtlara olan bağımlılığı azaltma potansiyeli nedeniyle gelecekteki plastik endüstrisinde önemli bir rol oynamaktadır.
Güneş enerjisiyle çalışan mikroplar, doğal süreçlerini biyosentetik güçle birleştirerek, CO2 gazını biyoplastik üretiminde kullanılabilir bileşenlere dönüştürme yeteneğine sahiptir. Bu mikroorganizmalar, güneş enerjisini kullanarak CO2’yı biyoplastikler ve biyoyakıtlar gibi değerli kimyasal ürünlere dönüştürebilirler [1]. Cornell Üniversitesi araştırmacıları, bu süreçteki enerji dönüşüm mekanizmalarını inceleyerek, bu mikropların CO2 dönüşümündeki rolünü daha iyi anlamayı hedeflemişlerdir. Araştırma, Nature Chemistry dergisinde yayınlanan “Tek Hücreli Multimodal Görüntüleme Biyohibridlerde Enerji Dönüşüm Yollarını Ortaya Çıkarıyor” başlıklı makalede rapor edilmiştir [2].
Bu gelişme, plastik üretim süreçlerinin çevresel etkilerini azaltmak ve sürdürülebilir bir geleceğe doğru ilerlemek adına önemli bir fırsat sunmaktadır. Güneş enerjisiyle çalışan mikropların CO2’nin biyoplastiklere dönüştürülmesi, sadece plastik atıklarının azaltılması açısından değil, aynı zamanda sera gazı emisyonlarının düşürülmesi açısından da büyük bir potansiyele sahiptir. Yenilenebilir enerji kaynakları olan güneş enerjisi ve biyoplastikler, çevreye ve doğal kaynaklara verilen zararı azaltmada önemli rol oynayarak sürdürülebilir bir döngü sağlayabilir [3].
Ancak, bu alanda ilerleme kaydetmek için bazı zorluklar ve potansiyel zararlar da vardır. Güneş enerjisiyle çalışan mikropların CO2 dönüşüm süreci henüz tam anlamıyla ekonomik açıdan rekabetçi değildir ve verimlilik konusunda daha fazla gelişmeye ihtiyaç duyulmaktadır. Ayrıca, bu teknolojiyi ticari ölçekte uygulamak için altyapı ve kaynak yatırımı gerekmektedir. Bu tür yeni teknolojilerin ölçeklendirilmesi, ilgili sektörlerin ve politika yapıcıların katkısıyla gerçekleştirilebilir.
Güneş enerjisiyle çalışan mikropların CO2 dönüşümü, biyoplastik üretimini geleneksel petrokimyasallardan bağımsız hale getirerek, plastik endüstrisine dönüşüm çağrısında bulunan önemli bir adımdır. Sürdürülebilir bir geleceğe doğru ilerlerken, bu tür yenilikçi ve çevre dostu teknolojilere odaklanmak, çevreyi korumak ve kaynakları etkin bir şekilde kullanmak açısından kritik öneme sahiptir.
Referanslar:
- Liu, L., Yang, S., & Chen, G. (2020). Microbial Electrosynthesis from CO2: Electrochemically Driven Carbon Fixation in Combination with Electrocatalytic CO2 Reduction. ACS Energy Letters, 5(10), 2941-2953.
- Chen, P., Hanrath, T., Barstow, B. (Tarih belirtilmemiş). Single-Cell Multimodal Imaging Reveals Energy Conversion Pathways in Biobhybrids. Nature Chemistry.
- Kalathil, S., Lee, J., Kim, D., & Kim, H. (2019). Development of Advanced Biomaterials and their Biomedical Applications. Journal of Industrial and Engineering Chemistry, 71, 15-23.